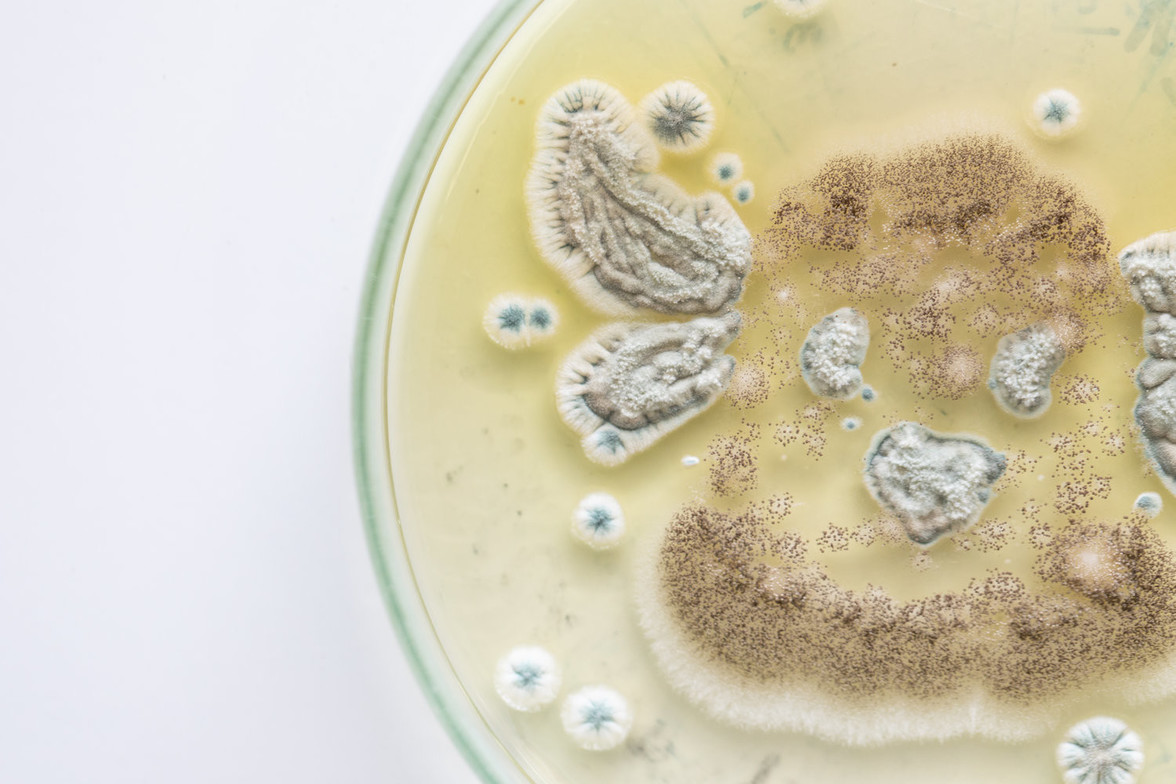
Ozone for Mold in San Diego

Mold exposure is a growing concern in San Diego, where moisture and humidity can contribute to hidden mold growth in homes and buildings. Chronic exposure to mold and mycotoxins can lead to serious health issues, including respiratory problems, chronic fatigue, neurological issues, and immune dysfunction. While traditional treatments focus on antifungal medications and environmental remediation, many individuals are turning to ozone therapy as a powerful tool for detoxification and recovery.
At Tulsi Wellness Club, we specialize in holistic healing approaches, including ozone therapy for mold toxicity. If you’ve been struggling with persistent symptoms related to mold exposure, ozone therapy may help support your body's natural detoxification processes and restore overall health.
Understanding Mold Toxicity
Mold exposure can occur in damp environments where spores grow on walls, ceilings, or HVAC systems. However, the most concerning aspect of mold is the mycotoxins—toxic compounds released by certain mold species that can have long-term health effects. These toxins can enter the bloodstream, leading to chronic inflammation, immune suppression, and neurological symptoms.
Common symptoms of mold exposure include:
Chronic fatigue
Brain fog and memory issues
Sinus congestion and respiratory problems
Joint and muscle pain
Skin rashes
Digestive disturbances
Mood swings and anxiety
Many individuals with mold toxicity experience persistent symptoms even after removing themselves from the moldy environment, making detoxification a critical step in recovery.
How Ozone Therapy Helps with Mold Toxicity
Ozone therapy uses medical-grade ozone (O3) to increase oxygen levels in the body, stimulate detoxification, and boost the immune system. This natural treatment can be beneficial for individuals suffering from mold-related illnesses by:
Enhancing Detoxification
Ozone therapy helps the body break down and eliminate mycotoxins by increasing oxygen utilization at the cellular level. Mycotoxins are fat-soluble, meaning they accumulate in tissues and are difficult to remove. Ozone therapy supports liver detox pathways, helping to flush out these harmful substances more effectively.
Boosting the Immune System
Mold exposure can weaken the immune system, making individuals more susceptible to infections and chronic inflammation. Ozone therapy activates white blood cells and enhances antioxidant production, strengthening the body’s natural defense mechanisms.
Reducing Inflammation
Chronic mold exposure leads to systemic inflammation, contributing to symptoms like pain, brain fog, and fatigue. Ozone therapy has anti-inflammatory properties that can help calm the immune system and promote healing.
Supporting Mitochondrial Function
Mold toxicity can damage mitochondria, the energy-producing centers of our cells, leading to chronic fatigue and low energy levels. Ozone therapy helps restore mitochondrial function, improving cellular energy production and reducing fatigue.
Addressing Respiratory Issues
For individuals experiencing sinus congestion, asthma, or respiratory issues due to mold exposure, ozone therapy can help by increasing oxygenation and reducing microbial load in the lungs and airways. Some patients also benefit from ozonated nasal treatments to target mold-related sinus infections.
Types of Ozone Therapy for Mold Detox
At Tulsi Wellness Club, we offer several ozone therapy methods to help with mold detoxification:
Major Autohemotherapy (MAH) – A small amount of blood is drawn, mixed with ozone, and reinfused into the body to enhance immune function and detoxification.
EBOO (Extracorporeal Blood Oxygenation and Ozonation) – A more advanced form of ozone therapy that deeply cleanses the blood and removes toxins.
Rectal Insufflation – A less invasive yet highly effective way to deliver ozone to the bloodstream and gut for detox support.
Nasal and Sinus Ozone Therapy – Direct ozone treatments can help with mold-related sinus infections and respiratory symptoms.
Why Choose Ozone Therapy for Mold in San Diego?
If you're in San Diego and struggling with mold-related symptoms, ozone therapy offers a natural, effective way to detoxify the body and regain your health. Many patients find that conventional treatments alone aren't enough to fully recover from mold toxicity. By addressing the root cause and supporting the body's natural healing abilities, ozone therapy can be a valuable part of your mold detox protocol.
At Tulsi Wellness Club, we provide personalized ozone therapy treatments designed to help you recover from mold exposure safely and effectively. If you're ready to take control of your health, we're here to guide you on your journey to wellness.
Contact us today to learn more about how ozone therapy can help you detox from mold and restore your vitality!
Dr. Devin Stone
Contact Me


